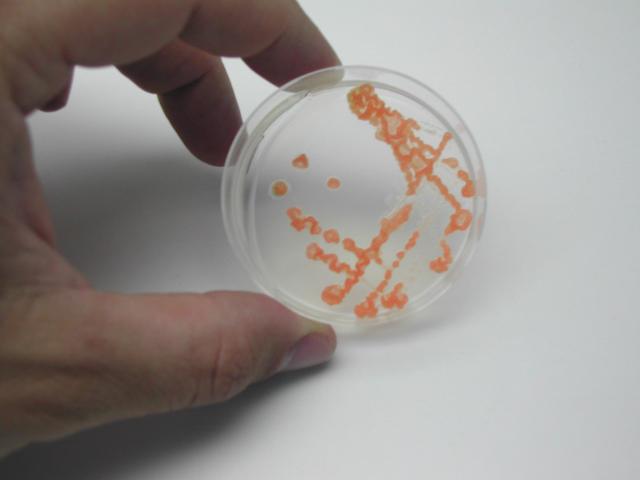
Hand holding a petri dish with red bacteria colonies. These are methane oxidizing bacteria.

G̶o̶o̶g̶l̶e̶r̶… ex-Googler.
Born in 1914, Hedy Lamarr was a famous American actress who pioneered the technology that would lead to WiFi, GPS, cell phones & Bluetooth communication.
Lamarr was brilliant. Among many fascinating inventions, she developed a new communication system with composer George Antheil that used “frequency hopping” among radio waves.
Once called the “most beautiful woman in the world," Lamarr is now remembered as "the mother of Wi-Fi."
if i ever come into possession of an EV with a "simulated engine noise" feature, i will hack it to add a simpsons hit and run exploded car soundscape
when activated, the car is capped to 15 km/h
You need a master degree in biogeochemistry, microbiology or related.
Find the vacancy on our website:
nioo.knaw.nl/en/vacancies/phd-…
#vacancy #Wageningen
PhD Climet: Microbial methane cycling in arctic lakes
You will be executing laboratory experiments which will be carried out in close cooperation with a post-doc to be recruited.nioo.knaw.nl
An interesting #PlantSciJob as Editor at Nature Microbiology @natmicrobiol.nature.com. Expertise in #PlantMicrobiology #MicrobialEcology #PlantImmunity desirable. #PlantScience #PlantSciJobs #PlantScienceJobs
Also FYI: these are cranks in #RFKjr's circles. Seneff is a long-standing antivax nutcase. Fagan is in cult--he's Raja of Food Purity or something.
You should take these claims just like those of the #antivaxxer level.
cen.acs.org/safety/consumer-sa…

Girl Scout cookies are safe to eat, scientists confirm
A recent chemical analysis of toxic substances in the popular treats is misleading, experts sayJason Bittel, special to C&EN (American Chemical Society)
@foaylward The same grifters do it all the time, because you can get press and attention by beating up on young girls' work.
SSDD
CALL for PAPERS: International Symposium-Workshop “Critical Ecologies: Crisis, Grief, and Resilience in Philosophy, Art, and Science”
The Eco- and Bioart Lab International Symposium-Workshop “Critical Ecologies: Crisis, Grief, and Resilience in Philosophy, Art, and Science” 2nd-3rd October 2025, Arbetets Museum, Norrköping Presently, climate change, species extinction and loss of biodiversity, destruction of habitats and ecosystems, epidemics, and slow environmental…
ecobioartlab.net/2025/04/08/ca…

CALL for PAPERS: International Symposium-Workshop “Critical Ecologies: Crisis, Grief, and Resilience in Philosophy, Art, and Science”
The Eco- and Bioart Lab International Symposium-Workshop “Critical Ecologies: Crisis, Grief, and Resilience in Philosophy, Art, and Science” 2nd-3rd October 2025, Arbetets Museum, Norrköping Presen…The Eco- and Bioart Lab
Stop wasting time mounting drives manually!
itsfoss.com/automount-drives-l…

Automounting External Drives in Linux
With just a little effort, automounting the external disk can significantly improve your computing experience by providing additional storage.Abhishek Kumar (It's FOSS)
This guy is hilariously fun!
Accordion electronica! Move over Weird Al!
like this
Iconic music samples from 1990-2024
like this
New OK Go song! If you don't like their music, just turn off the sound and enjoy another crazy wonderful video!
like this
However, if you take a careful look, you will find ways they have cleverly edited it, so that the poor hopping young man gets a few breaks!
youtu.be/mnHlGONToIc?si=ZkDGgu…
Andrew Pam likes this.
Open Call: Counter-Media Residency
Are you a media-maker interested in joining a community of scholars and practitioners at the intersection of religion and media studies? CU Boulder's Center forCenter for Media, Religion and Culture
Systemd's own Linux distro!? 😮
news.itsfoss.com/systemd-parti…

ParticleOS: Systemd's Very Own Linux Distro in Making
A Linux distro from systemd? Sounds interesting, right?Sourav Rudra (It's FOSS News)
Why do AI company logos look like buttholes?
A humorous exploration of the uncanny resemblance between AI company logos and human anatomy. Discover why circular, gradient-based designs dominate the AI industry, and what this design convergence tells us about branding in tech.velvetshark.com
Researcher uncovers dozens of sketchy Chrome extensions with 4 million installs
Make Sure You Haven't Gotten Caught By These Sketchy Chrome Extensions
#ArsTechna #Chrome #Extensions #TrojanExtensions #ComputerSecurity

Researcher uncovers dozens of sketchy Chrome extensions with 4 million installs
Even weirder: Why would Google give so many the “Featured” stamp for trustworthiness?Dan Goodin (Ars Technica)
like this
El Archivo de Imágenes de Dominio Público, presentado por The Public Domain Review, es una colección de + de 10.000 imágenes históricas en dominio público que se pueden reutilizar libremente.
+ de 2.000 años de cultura visual.
What's at stake with mass surveillance? 🕵🏼
Constanze Kurz argues that we've lost momentum since the #Snowden revelations in 2013... With intelligence services growing more powerful, here's what matters for our collective digital future:
youtube.com/watch?v=veqaibJ4K1…
- YouTube
Enjoy the videos and music that you love, upload original content and share it all with friends, family and the world on YouTube.www.youtube.com
Another update to our anti-cheat compatibility page. Users logged in can send in a request for a game to be listed now too, on top of the reports for existing games added earlier: gamingonlinux.com/anticheat/

GamingOnLinux Anti-Cheat Compatibility List for Steam Deck and Linux
A page dedicated to showing you the expected compatibility for Steam Deck and Linux desktop with games that have anti-cheat enabled.GamingOnLinux
Species Richness and Speciation Rates for all Terrestrial Animals Emerge from a Synthesis of Ecological Theories
The latest Marvel Rivals update is causing problems on Linux - here's a quick workaround gamingonlinux.com/2025/04/the-…
#MarvelRivals #Linux #LinuxGaming

The latest Marvel Rivals update is causing problems on Linux - here's a quick workaround
Marvel Rivals has been updated with Season 2 by NetEase Games which brings in a new experimental shader compiler mode and other new content. However, it's causing problems for Desktop Linux players where nothing appears after hitting play.Liam Dawe (GamingOnLinux)

GamingOnLinux Anti-Cheat Compatibility List for Steam Deck and Linux
A page dedicated to showing you the expected compatibility for Steam Deck and Linux desktop with games that have anti-cheat enabled.GamingOnLinux
From that one time I saw the most perfect window scene and felt obligated to capture it.
I was inside the capital building of Antigua #Guatemala and as I walked up the stairs I looked out the stairwell window to see this gorgeously framed flower pot. Someone had to have put it there on purpose! I particularly enjoy the effectively black canvas created by the dark interior behind.
#WindowFriday #feinsterfreitag #fineartphotography #artphotography #photography #fujifilm
Deep Rock Galactic: Survivor gets a release date and Deep Rock Galactic: Rogue Core gets a new trailer gamingonlinux.com/2025/04/deep…
#DeepRockGalactic #FPS #PCGaming #Linux #SteamDeck #RogueCore

Deep Rock Galactic: Survivor gets a release date and Deep Rock Galactic: Rogue Core gets a new trailer
There's a whole lot of space dwarf action going on lately. Deep Rock Galactic: Survivor now has a release date for the 1.0 release and we have new footage on the upcoming Deep Rock Galactic: Rogue Core too.Liam Dawe (GamingOnLinux)
A quick rundown of the APT 3.0 release!
youtube.com/watch?v=7cGxXfw8M7…
- YouTube
Enjoy the videos and music that you love, upload original content and share it all with friends, family and the world on YouTube.www.youtube.com
Maintenance updates for Nextcloud Hub 8 (29.0.15, EOL), 9 (30.0.9) and 10 (31.0.3) are available 🚀
Upgrade to a new version for better and even more secure Nextcloud experience. The updating process is designed to be and smooth - keep your server up to date!
nextcloud.com/blog/april-maint…

April maintenance updates: Nextcloud Hub 10 enterprise release and EOL of Nexcloud Hub 8 - Nextcloud
Maintenance updates are ready for Nextcloud Hub 8, 9 and 10. Read more about the updates and access the changelog.Mikhail Korotaev (Nextcloud)
Neverway is a horror RPG that blends action and life sim elements that looks incredible gamingonlinux.com/2025/04/neve…
#Neverway #IndieGames #Linux #SteamDeck

Neverway is a horror RPG that blends action and life sim elements that looks incredible
With funding from Outersloth, the publishing arm of the Among Us developer Innersloth, Neverway is a new reveal from Coldblood Inc.Liam Dawe (GamingOnLinux)
Smash-hit drug sim Schedule I plans full Steam Deck support, will use the Steam Deck as the "performance benchmark" gamingonlinux.com/2025/04/smas…
#ScheduleI #SteamDeck #Linux #Gaming #PCGaming

Smash-hit drug sim Schedule I plans full Steam Deck support, will use the Steam Deck as the "performance benchmark"
Schedule I is high up on my wishlist to eventually play-through, thankfully being in Early Access I've got plenty of time to get to it and it's only going to get better with full Steam Deck support planned.Liam Dawe (GamingOnLinux)
Everything to grab from Prime Gaming, April 11th edition for Steam Deck / Linux gamingonlinux.com/2025/04/ever…
#Gaming #PrimeGaming #Amazon #PCGaming

Everything to grab from Prime Gaming, April 11th edition for Steam Deck / Linux
Here's the up to date list of games available on Amazon Prime Gaming for April 11th, and what compatibility you can expect for Linux / SteamOS and Steam Deck.Liam Dawe (GamingOnLinux)
Comedy narrative-driven isometric adventure Paradigm Island in need of Linux testers gamingonlinux.com/2025/04/come…
#ParadigmIsland #IndieGame #Linux #SteamDeck #Gaming

Comedy narrative-driven isometric adventure Paradigm Island in need of Linux testers
Paradigm Island developers End-all Entertainment are looking for Linux testers of their upcoming comedy narrative-driven isometric adventure.Liam Dawe (GamingOnLinux)
Vampire Survivors free Square Enix SaGa cross-over DLC, another free update and cross-save out now gamingonlinux.com/2025/04/vamp…
#VampireSurvivors #IndieGame #Linux #SteamDeck

Vampire Survivors free Square Enix SaGa cross-over DLC, another free update and cross-save out now
Vampire Survivors just had two entirely free content drops! The first is a free DLC cross-over with Square Enix's SaGa series, along with a chicken-themed free update.Liam Dawe (GamingOnLinux)

AlexanderVI
in reply to Sheril Kirshenbaum • • •Massimiliano Siddi
in reply to Sheril Kirshenbaum • • •Robin Barton
in reply to Sheril Kirshenbaum • • •RedAlert (Michael)
in reply to Sheril Kirshenbaum • • •#keinvergessen
#KämpfenBeginntMitErinnern
#niewiederfaschismus
#niewiederistjetzt ‼️
#AllezusammengegendenFaschismus
#afdverbotsverfahrenjetzt
#stopptDieBrandstifter
#WirSindDieBrandmauer
moon77
in reply to Sheril Kirshenbaum • • •Chris
in reply to Sheril Kirshenbaum • • •Chukwuemeka
in reply to Sheril Kirshenbaum • • •Draken BlackKnight
in reply to Sheril Kirshenbaum • • •Wulfy—Speaker to the machines
in reply to Sheril Kirshenbaum • • •David P
in reply to Sheril Kirshenbaum • • •There's a doco about her:
en.wikipedia.org/wiki/Bombshel…
documentary film by Alexandra Dean
Contributors to Wikimedia projects (Wikimedia Foundation, Inc.)Jumping Mouse
in reply to Sheril Kirshenbaum • • •cliffordheath
in reply to Sheril Kirshenbaum • • •MegatronicThronBanks
in reply to Sheril Kirshenbaum • • •Joe Hill 🇵🇸🇺🇦
in reply to Sheril Kirshenbaum • • •Someone needs to invent a “Decades” filter app for photographs. It would be interesting to see Hedy, Marilyn, Joan Crawford, etc how they would look in the 70’s, 80’s, 90’s etc.
I wanna see Rave Hedy from the 2010’s.
Leti66 🇮🇹
in reply to Sheril Kirshenbaum • • •Gerhardf
in reply to Sheril Kirshenbaum • • •Mohammadayaz AMIRI
in reply to Sheril Kirshenbaum • • •hanktank61
in reply to Sheril Kirshenbaum • • •Talking about that to her, she always mentioned Hedi Lamarr as her favorite. Never saw her in anything, probably to difficult for Dutch TV 1960 s .
Only later I learned about her other life.
I volunteer in a mixed team on a cultural public spot.
When talking about that I always show your promoting posts 😀
xs4me2
in reply to Sheril Kirshenbaum • • •Cheshire Lunar Kitten
in reply to Sheril Kirshenbaum • • •Right?